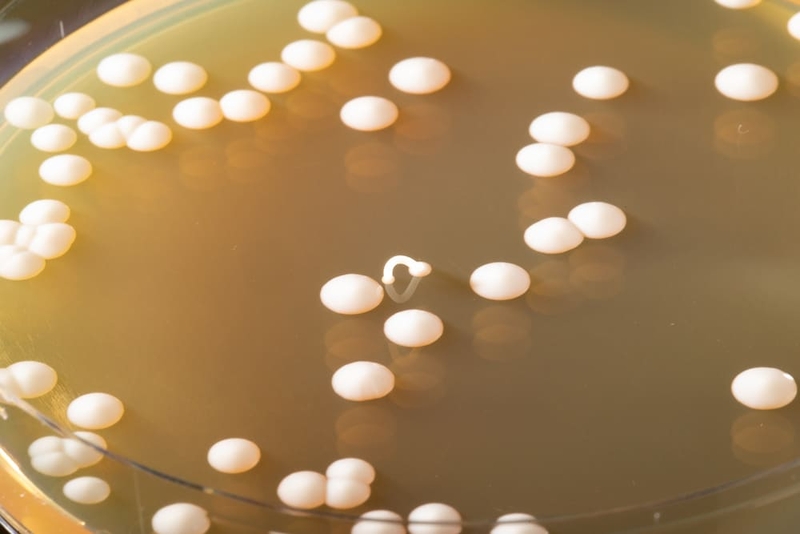
Điều trị nấm miệng ở trẻ 2 tuổi 1

Dược sĩ chuyên ngành Dược lâm sàng, với nhiều năm kinh nghiệm làm việc trong lĩnh vực dược phẩm. Là Dược sĩ Long Châu đạt được chứng chỉ bệnh học cấp quốc tế. Hiện đang là giảng viên tại Trung tâm Đào tạo FPT Long Châu.
Một số lưu ý khi điều trị nấm miệng ở trẻ 2 tuổi
28/06/2023
Mặc định
Lớn hơn
Nấm miệng ở trẻ khiến không ít bố mẹ phải lo lắng. Vậy làm thế nào để có thể điều trị nấm miệng ở trẻ 2 tuổi dứt điểm để trẻ ăn uống được bình thường trở lại và cải thiện sức khỏe răng miệng cho trẻ.
Nấm miệng ở trẻ em có thể tái đi tái lại nhiều lần. Nguyên nhân thường là do hệ thống miễn dịch và sức đề kháng của trẻ chưa phát triển hoàn thiện. Vậy cần điều trị nấm miệng ở trẻ 2 tuổi như thế nào?
Nguyên nhân dẫn đến tình trạng nấm miệng ở trẻ
Nguyên nhân gây nên tình trạng nấm miệng ở trẻ là do loại nấm Candida Albican. Trẻ có thể bị nhiễm loại nấm này bởi nhiều lý do như:
- Vệ sinh: Trẻ không được vệ sinh răng miệng thường xuyên và đúng cách.
- Do các vật dụng sinh hoạt: Đồ chơi, núm ti, chén, muỗng,... dùng cho trẻ không được giữ gìn và làm sạch kỹ sẽ trở thành nơi trú ngụ lý tưởng của vi khuẩn, nấm mốc.
- Hệ thống miễn dịch yếu: Trong những năm đầu đời, hệ thống miễn dịch vẫn còn non nớt khiến trẻ dễ mắc các bệnh truyền nhiễm.
- Lây nhiễm từ mẹ: Nếu cơ thể mẹ mắc bệnh nấm sinh dục chưa được điều trị triệt để, bé có thể bị lây từ mẹ trong quá trình sinh nở.
Hình ảnh nấm Candida Albican dưới kính hiển vi
Hình ảnh nấm Candida Albican dưới kính hiển viTriệu chứng nhận biết trẻ bị nấm miệng
Để nhận biết được trẻ có bị nấm miệng hay không, ba mẹ nên theo dõi các triệu chứng sau đây:
- Trẻ thường xuyên có dấu hiệu khó chịu, muốn đưa tay vào miệng do ngứa ngáy, quấy khóc khi ăn uống, thậm chí bỏ bú/bỏ ăn.
- Các đốm hoặc mảng trắng trông giống như bựa răng, mảng bám nhưng khó làm sạch nhưng thường không đau.
- Soi họng có thể thấy nhiều đốm hoặc các mảng màu trắng xốp ở lưỡi, lợi, mặt trong má, vòm họng, amidan, thành sau họng.
 Điều trị nấm miệng ở trẻ 2 tuổi khiến nhiều bố mẹ lo lắng
Điều trị nấm miệng ở trẻ 2 tuổi khiến nhiều bố mẹ lo lắngCách điều trị nấm miệng ở trẻ 2 tuổi
Điều trị nấm miệng ở trẻ 2 tuổi cần phải thực hiện dứt điểm, nếu bố mẹ chủ quan sẽ rất dễ khiến tình trạng tái phát nhiều lần, có nguy cơ cao lan rộng đến các cơ quan khác như thực quản, khí quản,... và dẫn đến các biến chứng khác như viêm phổi, nhiễm trùng huyết,...
Để quá trình điều trị trẻ bị nấm miệng hiệu quả, ba mẹ nên đưa trẻ đến các trung tâm y tế để được các bác sĩ thăm khám, tư vấn và điều trị theo phác đồ thích hợp.
Không nên tự ý dùng thuốc cho trẻ để phòng các tác dụng phụ của thuốc, hoặc khiến cho bệnh thêm nghiêm trọng hơn.
Một số loại thuốc thường được chỉ định điều trị như sau:
- Ketoconazole: Thuống kháng nấm dành cho trẻ 4 tháng đến 2 tuổi.
- Dung dịch Nystatin: Dung dịch rơ lưỡi dành cho trẻ, được dùng 4 lần/ngày và tối thiểu 7 ngày.
- Itraconazole, Amphotericin B: Thuốc kháng nấm dành cho trường hợp trẻ bị nấm miệng nặng.
Lưu ý trong khi điều trị trẻ bị nấm miệng
Trong quá trình điều trị nấm miệng ở trẻ 2 tuổi, ba mẹ nên lưu ý một số điều sau đây.
- Giữ vệ sinh sạch sẽ.
- Rửa tay kỹ, đeo găng tay trước khi tiến hành bôi thuốc hay vệ sinh cho trẻ.
- Hạn chế tiếp xúc với đờm dãi từ miệng trẻ.
- Vệ sinh ngực sạch sẽ trước và sau khi cho trẻ bú.
- Bảo quản tốt những vật dụng sinh hoạt của trẻ như bình sữa, núm, ti giả, chén, muỗng, đồ chơi,...
Thực hiện rơ miệng đúng cách:
Để hạn chế tình trạng buồn nôn khi rơ miệng cho trẻ, ba mẹ nên thực hiện rơ miệng khi trẻ đang đói vì khi đó, dạ dày của trẻ đang rỗng và nên thực hiện thao tác rơ từ ngoài vào trong
- Rửa tay sạch trước và sau khi rơ miệng cho trẻ.
- Nếu nấm miệng xuất hiện ở nhiều vị trí khác nhau, ba mẹ nên rơ theo thứ tự từ hai bên má đến vòm miệng và lưỡi.
 Luôn đảm bảo vệ sinh thật sạch cho trẻ
Luôn đảm bảo vệ sinh thật sạch cho trẻChế độ dinh dưỡng cho trẻ bị nấm miệng
Thực phẩm trẻ nên ăn
Khi trẻ bị nấm miệng, việc bổ sung thêm chất dinh dưỡng để cải thiện sức đề kháng và hệ miễn dịch cho trẻ là điều hết sức cần thiết để có thể kìm hãm được sự phát triển của nấm Candida Albican. Những thực phẩm trẻ nên ăn trong gia đoạn điều trị là:
- Rau củ: Nên chọn các loại rau củ có màu xanh đậm như súp lơ xanh, rau bina, bắp cải, xà lách, rau cải ngọt,...
- Trái cây: Các vitamin và chất khoáng trong trái cây có tác dụng hỗ trợ rất tốt cho hệ miễn dịch. Vì vậy, bố mẹ nên cho trẻ dùng nhiều các loại trái cây (lưu ý độ chua nhẹ và mềm) như kiwi, nho, táo, quýt, măng cụt,...
- Sữa chua: Bổ sung thêm lợi khuẩn cần thiết cho hệ tiêu hóa, giúp trẻ hấp thu tốt các chất dinh dưỡng.
Các loại thực phẩm nên hạn chế khi trẻ bị nấm miệng
Đối với trẻ đang bị nấm miệng, ba mẹ nên hạn chế cho trẻ ăn các thực phẩm như sau:
- Đường: Bánh, kẹo, mạch nha, nước có gas,...
- Hải sản: Cá biển, tôm, cua, ghẹ, hàu...
- Các thực phẩm kích thích vị giác mạnh: Tỏi, ớt, tiêu,...
Việc chăm sóc khi điều trị nấm miệng ở trẻ 2 tuổi rất quan trọng, giúp đảm bảo bệnh được điều trị triệt để, ngăn ngừa nguy cơ tái phát. Qua bài viết trên đây, mong rằng bố mẹ đã nắm được những thông tin hữu ích để chăm sóc và bảo vệ sức khỏe cho trẻ.
Hằng Lê
Nguồn thông tin: Tổng hợp
Có thể bạn quan tâm
Các bài viết liên quan
Hình ảnh nấm lưỡi ở người lớn dễ nhận biết và cách xử lý an toàn
Mụn trắng ở lợi trẻ sơ sinh: Nguyên nhân và phương pháp điều trị
Lớp màng nhầy màu trắng bên trong miệng phát sinh do đâu?
Ngứa lưỡi: Triệu chứng nói lên sức khỏe không ổn định của bạn
Cuống lưỡi nổi mụn đỏ: Nguyên nhân, triệu chứng, cách khắc phục và phòng ngừa
Môi nổi hạt sần sùi có thể là dấu hiệu của bệnh gì?
Top 4 thuốc trị nấm lưỡi hiệu quả và an toàn bạn nên biết
Bật mí những cách rơ lưỡi cho trẻ sơ sinh sạch khuẩn
Cách chăm sóc nấm miệng ở trẻ 4 tuổi như thế nào là đúng?
Mẹo chữa nấm miệng ở trẻ 1 tuổi bằng nguyên liệu tự nhiên an toàn
:format(webp)/Option_1_2_2d9677e5fd.png)
:format(webp)/Option_1_1_2a84e0cd00.png)
:format(webp)/duoc_si_kim_654f239621.png)